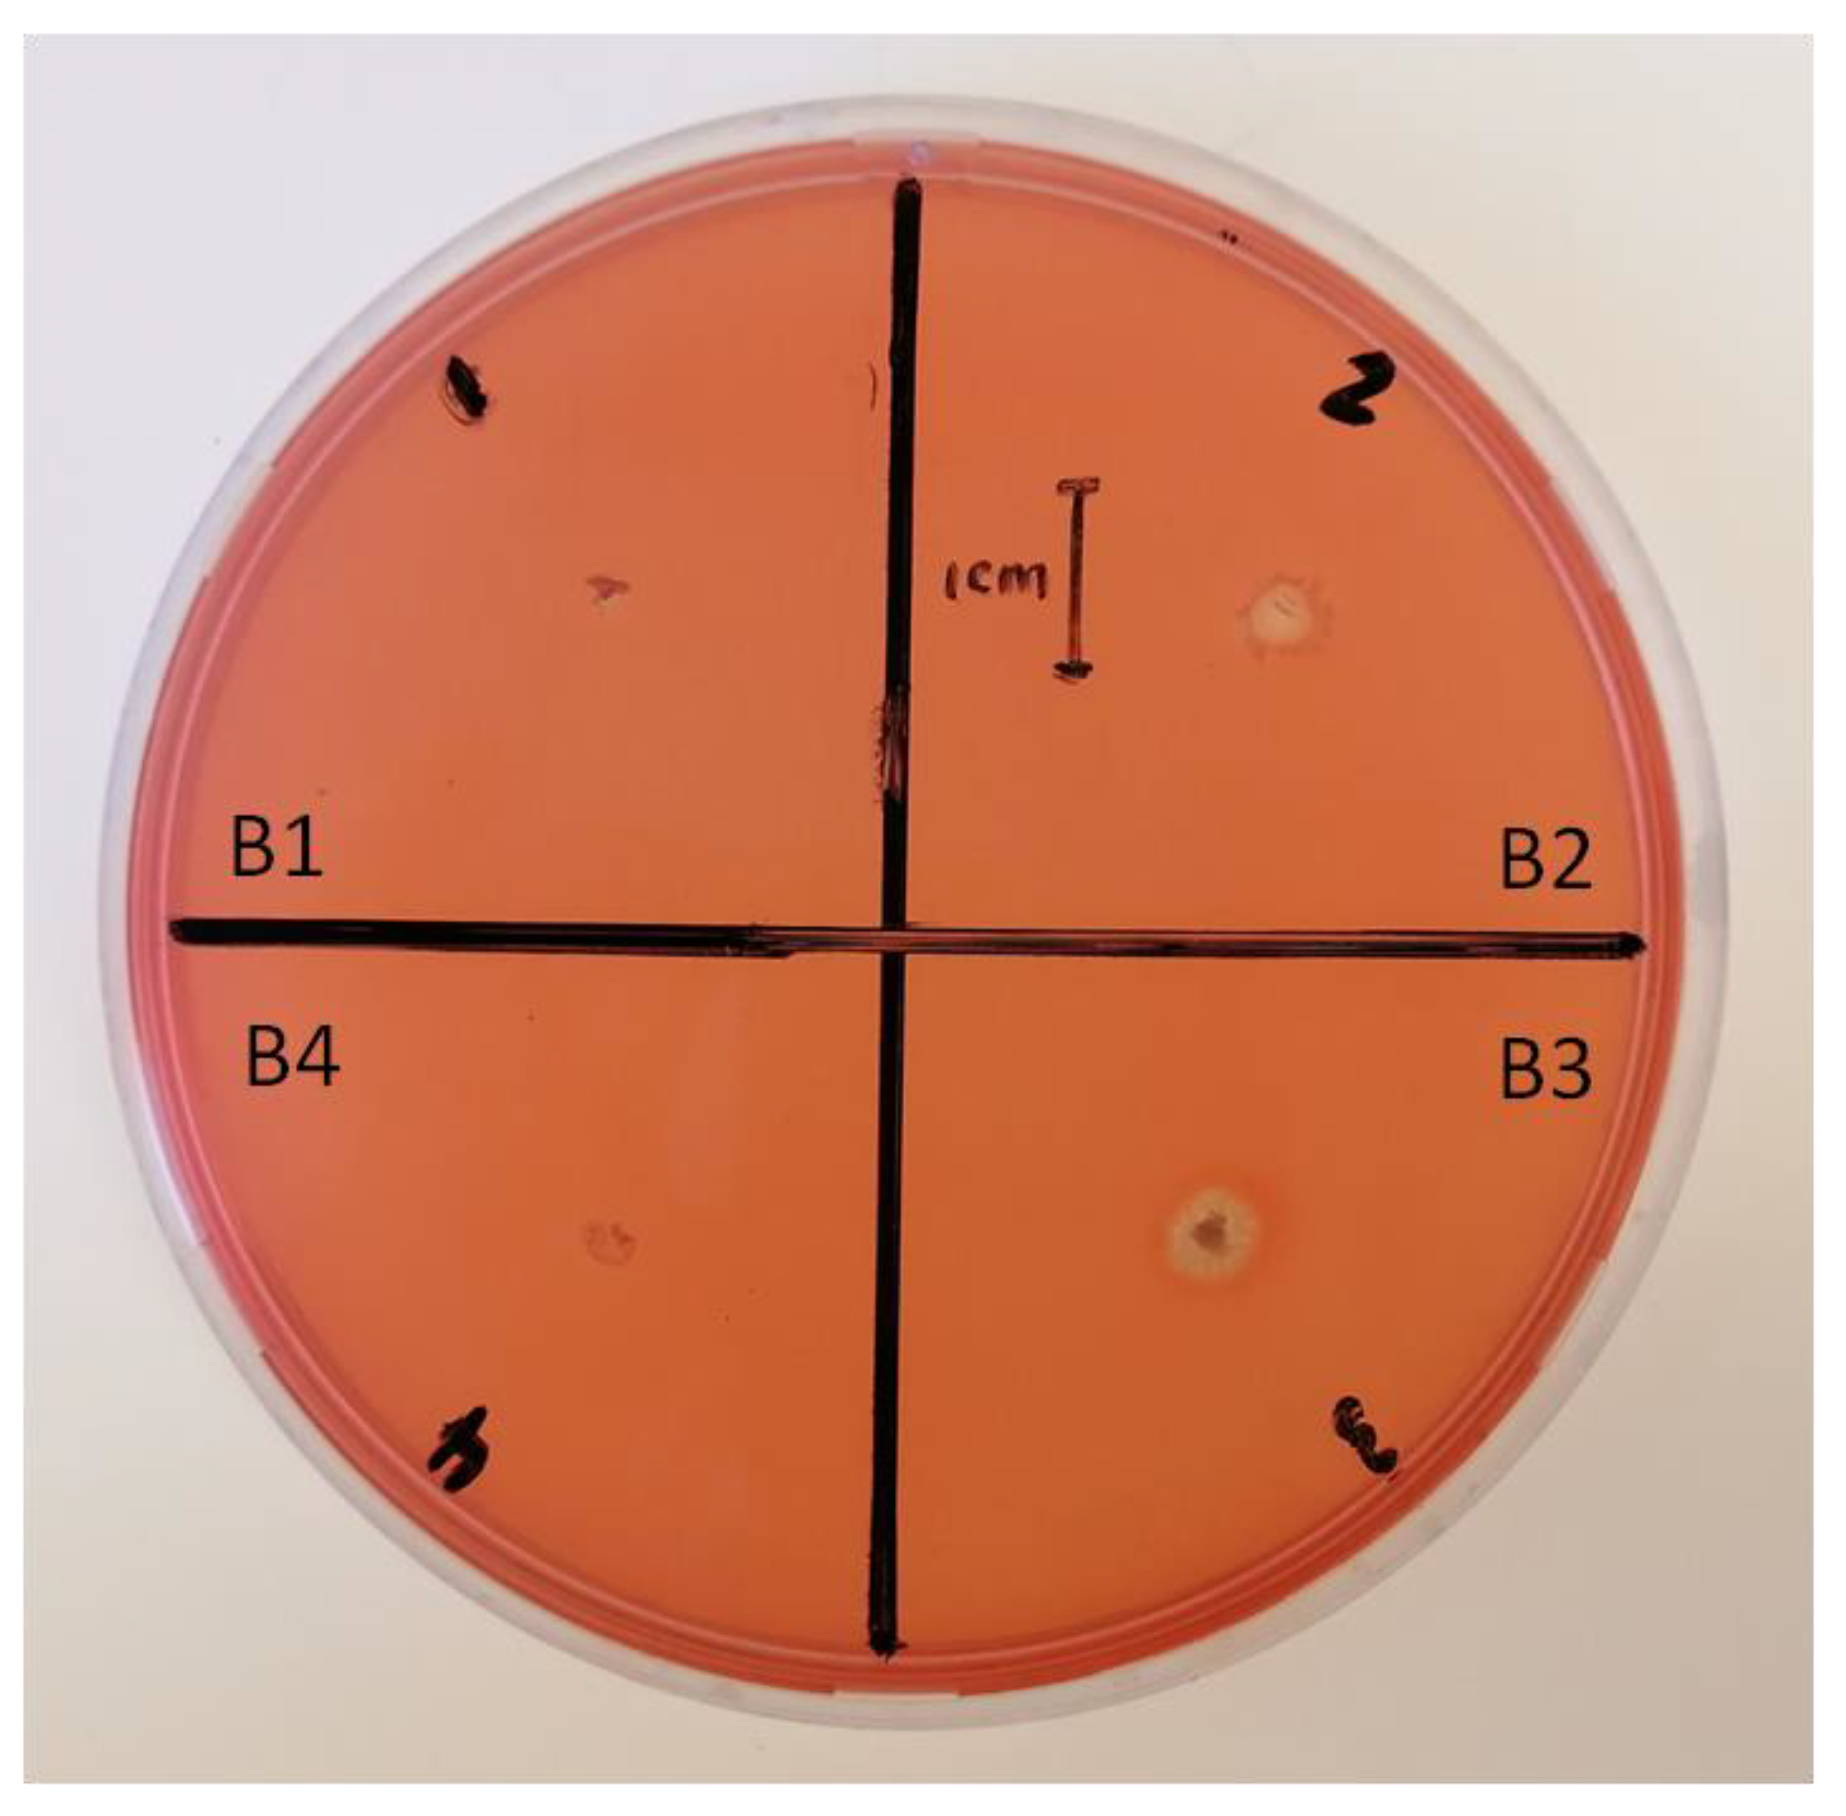
Pathogens 12 00254 g007 Pathogens 12 00254 g007

Abstract
The use of biological control agents as opposed to synthetic agrochemicals to control plant pathogens has gained momentum, considering their numerous advantages. The aim of this study is to investigate the biocontrol potential of plant bacterial isolates against Fusarium oxysporum, Fusarium proliferatum, Fusarium culmorum, and Fusarium verticillioides. Isolation, identification, characterization, and in vitro biocontrol antagonistic assays of these isolates against Fusarium species were carried out following standard protocols. The bacterial endophytes were isolated from Glycine max. L leaves (B1), Brassica napus. L seeds (B2), Vigna unguiculata seeds (B3), and Glycine max. L seeds (B4). The bacterial isolates were identified using 16S rRNA PCR sequencing. A phylogenetic analysis shows that the bacterial isolates are closely related to Bacillus subtilis (B1) and Bacillus tequilensis (B2–B4), with an identity score above 98%. All the bacterial isolates produced a significant amount (p < 0.05) of indole acetic acid (IAA), siderophores, and protease activity. In vitro antagonistic assays of these isolates show a significant (p < 0.05) growth inhibition of the fungal mycelia in the following order: F. proliferatum > F. culmorum > F. verticillioides > F. oxysporum, compared to the control. The results suggest that these bacterial isolates are good biocontrol candidates against the selected Fusarium species.
1. Introduction
As the world population multiplies, there is a need to improve agricultural productivity and reduce global food production losses by controlling crop pests and disease outbreaks [1]. One of the major causes of significant losses in food production is crop pathogens [2,3]. Fungal pathogens are a substantial cause of crop losses, producing millions of spores that affect pre- and post-harvest crops [4]. The genus Fusarium is one of the most significant biological stressors affecting economically essential crops in South Africa [5]. The genus contains filamentous fungi from the phylum Ascomycota, and is found in soil, water, and air. They are one of the most diverse and widespread fungal pathogens, causing various diseases such as rots, blights, wilts, and cankers [6]. Fusarium species are known to infect a variety of staple crops such as corn, wheat, and soybeans worldwide, impacting the environment, animals, and human health.
The major Fusarium species that infect many foods and feed crops include F. oxysporum, F. culmorum, F. verticillioides, and F. proliferatum. F. oxysporum is one of the most critical soil-borne plant pathogens as it infects many crops and is responsible for massive crop losses [7]. F. culmorum is known to infest wheat worldwide, causing wheat blight and crown rot of cereals, resulting in detrimental losses of this economically important crop [8,9]. F. verticillioides causes ear rot, stalk rot, and seedling blight in maize, resulting in significant economic losses in maize production worldwide [10]. F. proliferatum is associated with maize and soybean infections and has been reported to be a significant source of mycotoxin contamination in food [11]. The Fusarium species are known to produce mycotoxins such as deoxynivalenol, fumonisin-B1, moniliformin, and beauvericin, which are detrimental to plant, human, and animal health [12].
A key issue in agriculture is the sustainable reduction of the post-harvest yield across the food supply chain from harvest to consumption [13]. Several management strategies, including the use of agrochemicals, have been employed to minimize yield loss but have proved ineffective, due to the development of resistance as a result of continued usage, and the negative impact on the environment [14]. Copper-based fungicides can affect soil fertility and organisms due to the accumulation of copper in the soil, as copper is not biodegraded [15]. These chemicals used as fungicides are carcinogenic and can affect non-target organisms such as humans, animals, and other soil microbes such as nematodes, non-pathogenic bacteria, and fungi [16]. The role of these soil microbes includes the decomposition of organic matter, soil aeration, and the promotion of nutrient and water cycling in the soil, which has a positive effect on the soil composition and productivity [15].
Endophytes have long attracted interest as biocontrol agents (BCAs) due to their environmental friendliness, low cost, and reduced dependence on agrochemicals. Bacterial endophytes are efficient BCAs because they have adapted to live in plants and are self-sustaining [17]. Bacterial endophytes colonize the internal tissues of plants and live symbiotically without causing disease [18]. Endophytes benefit the host by stimulating plant growth and stress tolerance and protecting the host from disease and infection by pathogens [3]. They achieve this through mechanisms such as the competition for nutrients and space, the production of secondary metabolites, and plant hormone synthesis. These exudates or secondary metabolites play an active role in root–root and root–microbe interaction by influencing the biological and physical interactions between these interacting organisms. These metabolites can alter the physical, chemical, and biological properties of the soil and inhibit the growth of competing plant species [19]. Bacterial endophytes may use a combination of one or more of these metabolites to enhance pathogen inhibition and decrease the development of resistance [20].
The use of BCAs to control different Fusarium species has been reported [20]. Despite numerous studies on the inhibition potential of BCAs against the growth of the Fusarium species, there is a need to screen more biocontrol agents to add to the existing body of knowledge and increase awareness on their usage [21,22]. Therefore, this study aims to investigate the biological control potential of plant-associated bacterial endophytes against different Fusarium species in vitro. Several pathogenic soil-borne Fusarium species are susceptible to competition from plant-associated microbes [23]. The positive test for siderophore activity, protease activity, and chitinase activity could explain the mechanisms involved in suppressing the mycelial growth in the Fusarium species in this study.
2. Materials and Methods
2.1. Isolation of Endophytic Bacteria
Bacterial endophytes were isolated from surface-sterilized canola (Brassica napus L.), cowpea (Vigna unguiculata) seeds, soybean (Glycine max) seeds, and leaves that were cultured on potato glucose agar (PGA) media. A single colony from each bacterial isolate was sub-cultured into Luria–Bertani (LB) broth and incubated overnight at 37 °C.
2.2. DNA Extraction and PCR Amplification of the 16S rRNA Gene
High molecular weight genomic DNA was extracted from the bacteria isolates using the acetyl trimethylammonium bromide (CTAB) procedure, previously described by Murray and Thompson [24], with slight modifications. A single colony from each bacterial isolate inoculated in LB broth was centrifuged at 13,000 rpm for 5 min using an Eppendorf microcentrifuge (5425 R, Stevenage, UK), and the pellet was re-suspended in 300 µL of 1 × Tris-EDTA (TE) buffer. The sample was incubated at 65 °C for 15 min with 50 µL of 10% sodium dodecyl sulfate (SDS). After incubation, 500 µL of 1.5 × CTAB buffer and 5 µL of 2-mercaptoethanol was added. The samples were incubated at 65 °C for 1 h before adding an equal volume of chloroform: isopropanol (24:1), and they were centrifuged at 13,000 rpm for 15 min using an Eppendorf microcentrifuge (5425 R, Stevenage, UK) before transferring the upper layer into a 2 mL Eppendorf tube. The DNA was precipitated with 0.6 mL ice-cold absolute ethanol for 1 h and centrifuged at 13,000 rpm for 2 min. The pellet was washed twice with 70% ice-cold ethanol and centrifuged at 13,000 rpm for 2 min. The pellet was allowed to air dry and was re-suspended in 10 µL of 1 × TE buffer until further use. The 16S rRNA gene was amplified by polymerase chain reaction (PCR) with universal primers: E9F (5′-GAG TTT GAT CCT GGC TCA G-3′) and U1510R (5′-GGT TAC CTT GTT ACA CTT-3′). A 25 µL PCR reaction mixture consisting of 2 µM forward primer, 2 µM reverse primer, 2 × Multiplex PCR Master mix (Qiagen, Hilden, Germany), and 25 ng/µL of genomic DNA was prepared. The control was prepared by adding distilled water instead of template DNA to the reaction mix. Samples were amplified using a T100TM thermal cycler (BioRad, Hercules, USA) with initial denaturation at 95 °C for 15 min, 34 cycles at 94 °C for 30 s, 55 °C for 30 s, 72 °C for 30 s, the final extension at 72 °C for 5 min, and holding for 4 °C. PCR products were separated on a 1% agarose gel at 90 V.
2.3. DNA Sequencing and Data Analysis
The PCR amplicons of the 16S rRNA gene were sequenced using the BrilliantDye™ Terminator v3.1 Cycle Sequencing on an ABI3500xL genetic analyzer (Inqaba Biotechnical Industries (Pty) Ltd., Pretoria, South Africa). The obtained sequence data were edited and aligned using the Clustal W multiple sequence alignment tool in BioEdit sequence alignment editor version 7.05 (Raleigh, NC, USA) (http://www.mbio.ncsu.edu/BioEdit/bioedit.html (accessed on 15 September 2022)) to generate a contiguous consensus sequence. An aligned contiguous consensus sequence of 16S rRNA gene was used for homology search by the basic local alignment search tool (BLAST) software (http://blast.ncbi.nlm.nih.gov, accessed on 15 September 2022) algorithm at National Center for Biotechnology Information (NCBI) to identify bacterial isolates (to species’ level) based on highest percentage similarity. The phylogenetic analysis of the 16S rRNA gene sequences of the isolates (B1-4) including outgroup sequence (Escherichia coli; JCM 16946) was performed using the Molecular Evolutionary Genetics Analysis (MEGA) version X software [25]. Bootstrap analysis was performed in MEGA X using 100 replicates.
2.4. Gram Stain and Bacterial Morphology
A smear loop of each bacteria culture was heat fixed onto a glass slide and Gram stained [26]. The slide was viewed under a light microscope. Gram-positive bacteria are identified with a purple color, and Gram-negative bacteria are identified with a red/pink color. The morphology of the bacterium was also observed.
2.5. Catalase Test
Catalase activity of bacterial endophytes was tested by placing a smear loop of each culture onto a glass slide and adding 3% hydrogen peroxide to each isolate [27]. The formation of bubbles indicates a positive catalase activity.
2.6. Indole Acetic Acid (IAA) Production Test
Indole-3-acetic acid (IAA) production was determined using a colorimetric assay previously described by Gordon and Weber [28]. The endophytic bacterial isolates were grown in Yeast Extract Mannitol (YEM) broth (mannitol 1%, yeast extract 0.1%, dipotassium phosphate 0.05%, magnesium sulphate 0.02%, sodium chloride 0.01%) that was supplemented with 0.1% tryptophan and YEM broth without the addition of tryptophan. The cultures were grown at 37 °C with shaking for 5 days. E. coli Krx (Promega, Madison, WI, USA) was used as a control to screen for IAA production. After incubation, the cultures were centrifuged for 15 min at 13,000 rpm, and the supernatant was used for IAA extraction. The supernatant was mixed with Salkowski reagent (1:2) and incubated in the dark for 30 min at room temperature. The samples were measured at 530 nm using a FLUOstar Omega UV-visible spectrophotometer (BMG LabTech GmbH, Ortenberg, Germany) to determine the concentration of IAA. The absorbances were compared to a standard of IAA diluted in YEM broth with a concentration ranging from 5 µg/mL to 100 µg/mL.
2.7. Phosphate Solubilization Test
A smear loop of each bacterial culture was spot inoculated on Pikovskaya’s phosphate agar and grown for 7 days at room temperature [29]. A phosphate-solubilizing microorganism, E. coli Krx, was used as a positive control. After incubation, colonies were observed for halos, which indicates phosphate solubilization capability.
2.8. Siderophore Plate Assay
Siderophore activity was tested as described by Alexander and Zuberer [30]. A smear loop of each bacterial culture was spot inoculated on chrome azurol S (CAS) media and incubated at room temperature for 7 days. A bacterium with siderophore activity, E. coli Krx, was used as a positive control with E. coli XL gold (Agilent, Santa Clara, CA, USA) as a negative control. A clear zone around the colonies indicates siderophore activity.
2.9. Protease Activity Test
Protease production was determined according to the method described by Etminani and Harighi [31]. A smear loop of each isolate culture was spot inoculated on skim milk agar and incubated at room temperature for 4 days. Bacillus licheniformis (ATCC 145080), a bacterium with protease activity, was used as a positive control while 7-day-old E. coli Krx was used as a negative control. Agar plates were monitored for the formation of a halo around the colonies.
2.10. Chitinase Activity Test
Chitinase activity was tested as described by Faramarzi et al. [32]. A smear loop of each bacterial isolate was spot inoculated onto the colloidal chitin agar and incubated at room temperature for 7 days. After incubation, agar plates were stained with 0.1% Congo red to visualize the positive clearance zone around the colonies.
2.11. Antifungal Activity of Bacterial Isolates
The fungal pathogens used in this study were obtained from the fungal culture collection from the Plant Protection Institute, Agricultural Research Council (ARC), Pretoria, South Africa. All Fusarium species were grown and maintained on potato glucose agar (PGA) at room temperature (25 ± 2 °C). A well-diffusion method was used to screen bacterial isolates for their ability to suppress the growth of four Fusarium species, F. oxysporum PPRI 19027, F. proliferatum MRC 2059, F. culmorum PPRI 10138, and F. verticillioides MRC 826. For each fungal strain, an agar plug (1.0 cm × 1.0 cm) of 7-day-old actively growing mycelia was placed at the center of a new PGA plate and was allowed to grow at 30 °C for 48 h. After 48 h, 100 µL of each bacterial endophyte culture was inoculated on PGA plates at four equidistant sites (5 mm wells), 3 cm apart from the Fusarium colonies in the center. The control plates were inoculated with 0.03% carbendazim, a commercial fungicide. All plates were incubated at 30 °C for approximately 12 days. The antagonistic effect of bacterial isolates on Fusarium species’ mycelial growth was measured on day 12.
2.12. Statistical Analysis
The data collected were analyzed using one-way analysis of variance (ANOVA) while treatment means were separated by the least significance difference (LSD) incorporated in the Statistical Package for Social Sciences (SPSS) (version 26, IBM, Armonk, NY, USA).
3. Results
3.1. PCR Amplification of the Bacterial Isolates
The extracted high molecular weight genomic DNA was used for identifying all bacterial isolates via PCR amplification and sequencing of the 16S rRNA gene. Figure 1 shows the positive PCR amplification of two Bacillus controls (Bacillus subtilis ATCC® 19659™ and Bacillus tequilensis NCTC 13306) and the bacterial isolates (B1, B2, B3, and B4) used in this study. The samples produced a band at 1500 bp when amplified using the 16S rRNA gene marker, with no visible signs of degradation or the presence of primer dimers.
Figure 1.
PCR amplification products of the 16S rRNA gene marker for Bacillus positive controls and bacterial isolates (B1–B4) used in this study. (Lane M: GeneRuler 1 kb DNA ladder; lane 1: negative control; whereas lane 3: Bacillus subtilis ATCC® 19659™; lane 4: Bacillus tequilensis NCTC 13306; lane 5: B1; lane 6: B2; lane 7: B3; and lane 8: B4).
3.2. Molecular Identification and Phylogenetic Analysis of Bacterial Isolates
The bacterial endophytes isolated from soybean leaves, canola, cowpea, and soybean seeds showed a high sequence similarity to Bacillus species, using the basic local alignment search tool (BLAST) against the non-redundant NCBI database (Table 1). A molecular analysis of isolates B1 and B2–B4 revealed a close phylogenetic relationship to Bacillus subtilis and Bacillus tequilensis, respectively (Figure 2). Based on the BLAST search against NCBI, isolate B1 shows a 98.35% similarity with the Bacillus subtilis strain S-8. In addition, isolate B2 shows similarity to the Bacillus tequilensis strain 127 (98.69%), whereas B3 and B4 showed similarity with Bacillus tequilensis km24 (97.84%) and Bacillus tequilensis A37 (98.50%), respectively (Table 1). The maximum likelihood approach was used to determine the phylogenetic relationship between the identified isolates and selected database sequences (Figure 2).
Table 1.
Identification of bacterial isolates based on 16S rRNA gene sequencing.
Figure 2.
Phylogenetic analysis of 16s rRNA sequences of isolates B1, B2, B3, and B4, with reference sequences from NCBI (Table 1) using the MEGA maximum likelihood method based on the Tamura–Nei model. The bootstrap values are expressed as a percentage of 100 replicates. Escherichia coli JCM 16946 was used as outgroup. The identified bacterial isolates and their top hits are underlined in red.
3.3. Biochemical Characterization of Bacterial Isolates
Four bacterial isolates (B1–B4) including a positive control, E. coli Krx, were quantitatively screened to produce IAA using tryptophan as a precursor for IAA. The result of the IAA production potentials of the bacterial isolates revealed that B3 produced the highest amount of IAA (5.05 μg/mL), followed by isolate B4 (5.02 μg/mL), which are significantly higher (p < 0.05) than the control strain (E. coli Krx), which produced 3.21 µg/mL IAA (Figure 3).
Figure 3.
IAA production of bacterial isolates. The letters a, b, c indicate statistically significant difference at p < 0.05. Bars with different letters are significantly different at p < 0.05.
Catalase activity of all the isolates shows that they are all positive to the test while the Gram stain reaction shows that the isolates are all Gram-positive with rod shapes (Table 2). The phosphate solubilization results showed that none of the bacterial isolates showed zones of clearance and, as a result, could not solubilize phosphate, relative to the positive control (E. coli Krx), which produced a clear halo around the bacteria (Table 2; Figure 4).
Table 2.
Biochemical characterization of the endophytic bacteria isolated from different plant tissue.
Figure 4.
Phosphate solubilization test showing isolates B1–B4 and control spot inoculated onto Pikovskayas agar. B1 represents Bacillus subtilis, whereas B2, B3, and B4 represent Bacillus tequilensis.
The isolates were capable of siderophore production, as indicated by clearance zones around the B1–B4 colonies (Figure 5). However, all isolates showed siderophore activity with a narrow zone of clearance ranging between 16.50 ± 0.25 and 21.20 ± 1.27 mm, which were significantly comparable (p < 0.05) with the control (21.20 ± 0.10 mm), as shown in Table 2.
Figure 5.
Siderophores activity of bacterial isolates on chrome azurol S media plates. B1 represents Bacillus subtilis, whereas B2, B3, and B4 represent Bacillus tequilensis.
All bacterial isolates, except B1, could produce protease activity, as indicated by the clearance zones around the colonies (Figure 6). A similar zone of clearance was produced by all the isolates, with B3 having the least zone of clearance (11.60 ± 0.42 mm), relative to the control (15.30 ± 0.75 mm) (Table 2).
Figure 6.
Protease-producing ability of bacterial isolates B1-B4 on skim milk agar as indicated by a zone of clearance around their colonies. B1 represents Bacillus subtilis, whereas B2, B3, and B4 represent Bacillus tequilensis.
The chitinase test shows that isolates B2 (5.10 ± 0.42 mm) and B3 (6.13 ± 0.71 mm) had a chitinase-producing ability with a clear zone around the colonies (Figure 7). This shows that these bacterial isolates have the potential to degrade chitin, which forms an integral part of fungal cell walls. However, no chitinase activity was detected for isolates B1 and B4.
Figure 7.
Chitinase-producing ability of the bacterial isolates grown on chitin agar. B1 represents Bacillus subtilis, whereas B2, B3, and B4 represent Bacillus tequilensis.
3.4. Biocontrol Activity of the Bacterial Isolates against Fusarium Species
Biocontrol activity of the bacterial isolates against four different Fusarium species shows significant inhibition (p < 0.05) of the fungi (Table 3, Figure 8) with F. proliferatum as the most inhibited by isolates B3 and B4 with a percentage inhibition of 60.75 ± 0.21 and 64.79 ± 0.40%, respectively. The results showed that all bacterial isolates significantly (p < 0.05) inhibit the mycelial growth of all the four Fusarium species (F. culmorum, F. proliferatum and F. verticillioides), preventing them from growing more than 3 cm in diameter, which was comparable to the positive control (carbendazim).
Table 3.
Percentage inhibition of Fusarium mycelia by the bacterial isolates.
Figure 8.
Biocontrol potential of bacterial isolates against four Fusarium species. B1 represents Bacillus subtilis, whereas B2, B3, and B4 represent Bacillus tequilensis.
4. Discussion
Bacillus species have been well-documented for their ability to enhance plant growth and protect host plants against pathogen infections [19]. Bacterial endophytes were isolated from some plant seeds and leaves to evaluate their biocontrol potential. The bacterial endophytes isolated from soybean leaves, canola, cowpea, and soybean seeds showed a high sequence similarity to Bacillus spp, using the BLAST analysis from the NCBI database. Isolates B1 and B2-B4 revealed a close phylogenetic relationship to Bacillus subtilis and Bacillus tequilensis, respectively (Table 1; Figure 2).
The bacterial endophytes possessed IAA activity using tryptophan as a precursor. IAA is known to aid cell division, elongation, and the overall growth of plants [33]. IAA may also indirectly improve phosphorus acquisition by increasing plant root growth [34]. All the bacterial isolates significantly produced IAA (p < 0.05), which is comparable with the control (Figure 3). According to a report by Patten and Glick [35], 1 nM to 1 pM of IAA could promote plant growth, which suggests that the amount of IAA produced by these bacterial isolates in this study is sufficient to influence plant growth.
Phosphorus is a macronutrient required for the growth and development of plants. Bacteria capable of solubilizing insoluble phosphate can increase soil quality and plant growth [31]. The result of this study shows that there is no evidence of phosphate solubilization by any of the bacterial isolates (Figure 4). The inability of the bacterial isolates to solubilize phosphate implies that they could not utilize this mechanism of phosphate solubilization pathways to inhibit the growth of the Fusarium species. The result presented in this study is in agreement with the findings of Almoneafy et al. [36], who reported the inability of B. subtilis strain D16 to solubilize phosphate.
Siderophore production is essential for adapting the plant to an iron-limiting environment and controlling phytopathogens by inhibiting iron availability to pathogens [37]. The result of this study shows that all the bacterial isolates produced significant siderophore activity, which is significantly lower (p < 0.05) than the control organism (Table 2; Figure 5). Siderophore production for iron competition has been recognized as a significant antagonistic trait in many BCAs against phytopathogens [38]. Some fungal pathogens may also synthesize siderophores; however, they have a much lower affinity than bacteria. As a result, these bacterial isolates can potentially outcompete pathogens such as the Fusarium species for the available iron [39].
Lytic enzymes, such as chitinases and proteases, can degrade fungal cell walls and inhibit fungal growth in vitro, showing direct antifungal properties [38]. In this study, except for B1, all the bacterial isolates have protease activity (Table 2; Figure 6), while only B2 and B3 show chitinase activity (Table 2; Figure 7). Several bacterial genera, such as Bacillus, Pseudomonas, and Serratia are known to suppress fungal pathogens by producing lytic enzymes [39]. Proteases are enzymes that hydrolyze peptide bonds between amino acids [40]. Most fungal cell walls contain chitin [41], which is broken down by bacterial lytic enzymes, such as chitinases, to utilize the dead material as nutrients [42]. Ramyabharathi and Raguchander [38] reported that the bacterial endophyte B. subtilis EPCO16 inhibits the mycelial growth of F. oxysporum in vitro by producing chitinase and protease. The isolate B1 from the current study did not produce protease activity because it could not hydrolyze peptide bonds between amino acids of the fungi using protease pathways; isolates B1 and B4 did not produce chitinase and would not be able to inhibit the growth of the Fusarium species using disruption of the fungal chitin walls but still inhibited the Fusarium species’ growth. This suggests that B1 and B4 can utilize other molecules or pathways to suppress the growth of fungal pathogens, such as the production of volatile compounds [43].
The mycelial growth of the four Fusarium strains, F. oxysporum PPRI 19027, F. culmorum PPRI 10138, F. proliferatum MRC 2059, and F. verticillioides MRC 826, was significantly inhibited (p < 0.05) by all the bacterial isolates after 12 days (Table 3, Figure 8). The inhibitory capacity of the bacterial isolates could be attributed to their ability to grow faster and suppress the fungal pathogens by efficiently competing for space and nutrients. Soil-borne pathogens, such as Fusarium, that infect plants through mycelia contact are generally more susceptible to competition by plant-associated microorganisms [23]. According to Bacon et al. [44], F. verticillioides infection in maize plants could be inhibited by Bacillus subtilis because they occupy the same ecological niche based on competitive exclusion.
5. Conclusions
In this study, we report the biocontrol potential of four plant bacterial isolates against F. oxysporum, F. proliferatum, F. culmorum, and F. verticillioides.
The bacterial isolates were identified as Bacillus subtilis and Bacillus tequilensis, which displayed various indirect mechanisms for plant growth promotion, including IAA production, extracellular hydrolytic enzyme activities, and in vitro antagonistic activities against four phytopathogenic Fusarium strains. Endophytic bacteria with plant-growth-promoting characteristics may provide a solution to sustainably improve crop yield. The results further showed that the isolated bacterial endophytes significantly inhibited the growth of the Fusarium species in this order: F. proliferatum > F. culmorum > F. verticillioides > F. oxysporum in the in vitro biocontrol assay. From this study, we conclude that the inhibitory activity of the bacterial isolates may be attributed to their ability to produce siderophore, protease, catalase, and chitinase activities, which have been reported to cause the inhibition of fungal pathogens. Although these attributes may contribute to the antifungal activity exhibited by the bacterial isolates, more research is needed to fully characterize the antimicrobial capacity of these isolates by evaluating their ability to produce volatile microbial compounds and other lytic enzymes, such as β-1,3-glucanase.
Author Contributions
Conceptualization, M.K. and A.K.; methodology, V.B.; software, A.I.D.; validation, A.I.D., O.O.B. and A.G.; formal analysis, V.B. and A.I.D.; investigation, V.B.; resources, M.K. and A.K.; data curation, V.B., M.N. and A.I.D.; writing—original draft preparation, V.B. and O.O.B.; writing—review and editing, V.B., O.O.B., A.I.D., A.G., M.N., M.K. and A.K.; visualization, V.B.; supervision, M.K. and A.K.; project administration, M.K. and A.K.; funding acquisition, M.K. and A.K. All authors have read and agreed to the published version of the manuscript.
Funding
This research was financially supported by the NRF to A.K. (grant numbers: 107023 and 115280), and M.K. (grant numbers: 116346 and 109083). Part of the research was funded by the DST-NRF Centre of Excellence in Food Security (Project ID: 170202); the Department of Science and Innovation (DSI); and the Technology Innovation Agency (TIA), distributed by GrainSA (GB0200065; GB0200066).
Institutional Review Board Statement
Not applicable.
Informed Consent Statement
Not applicable.
Data Availability Statement
Not applicable.
Acknowledgments
The authors would like to thank the University of the Western Cape for the infrastructure and administrative support.
Conflicts of Interest
The authors declare no conflict of interest.
References
- Savary, S.; Ficke, A.; Aubertot, J.-N.; Hollier, C. Crop losses due to diseases and their implications for global food production losses and food security. Food Secur. 2012, 4, 519–537. [Google Scholar] [CrossRef]
- Compant, S.; Duffy, B.; Nowak, J.; Clément, C.; Barka, E.A. Use of plant growth-promoting bacteria for biocontrol of plant diseases: Principles, mechanisms of action, and future prospects. Appl. Environ. Microbiol. 2005, 71, 4951–4959. [Google Scholar] [CrossRef] [PubMed]
- Latz, M.A.; Jensen, B.; Collinge, D.B.; Jørgensen, H.J. Endophytic fungi as biocontrol agents: Elucidating mechanisms in disease suppression. Plant Ecol. Divers. 2018, 11, 555–567. [Google Scholar] [CrossRef]
- Strange, R.N.; Scott, P.R. Plant disease: A threat to global food security. Annu. Rev. Phytopathol. 2005, 43, 83–116. [Google Scholar] [CrossRef] [PubMed]
- Beukes, I.; Rose, L.J.; Shephard, G.S.; Flett, B.C.; Viljoen, A. Mycotoxigenic Fusarium species associated with grain crops in South Africa-A review. South Afr. J. Sci. 2017, 113, 1–12. [Google Scholar] [CrossRef]
- Ohike, T.; Makuni, K.; Okanami, M.; Ano, T. Screening of endophytic bacteria against fungal plant pathogens. J. Environ. Sci. 2013, 25, S122–S126. [Google Scholar] [CrossRef]
- Dinolfo, M.I.; Castañares, E.; Stenglein, S.A. Fusarium-plant interaction: State of the art-a review. Plant Protect. Sci. 2017, 53, 61–70. [Google Scholar] [CrossRef]
- Hogg, A.; Johnston, R.; Johnston, J.; Klouser, L.; Kephart, K.; Dyer, A. Monitoring Fusarium crown rot populations in spring wheat residues using quantitative real-time polymerase chain reaction. Phytopathology 2010, 100, 49–57. [Google Scholar] [CrossRef] [PubMed]
- Scherm, B.; Balmas, V.; Spanu, F.; Pani, G.; Delogu, G.; Pasquali, M.; Migheli, Q. Fusarium culmorum: Causal agent of foot and root rot and head blight on wheat. Mol. Plant Pathol. 2013, 14, 323–341. [Google Scholar] [CrossRef]
- Cumagun, C.J.R.; Ramos, J.S.; Dimaano, A.O.; Munaut, F.; Van Hove, F. Genetic characteristics of Fusarium verticillioides from corn in the Philippines. J. Gen. Plant Pathol. 2009, 75, 405–412. [Google Scholar] [CrossRef]
- El-Sayed, R.A.; Jebur, A.B.; Kang, W.; El-Esawi, M.A.; El-Demerdash, F.M. An overview on the major mycotoxins in food products: Characteristics, toxicity, and analysis. J. Future Foods 2022, 2, 91–102. [Google Scholar] [CrossRef]
- PalmEro, D.; De Cara, M.; Nosir, W.; GálvEz, L.; Cruz, A.; WooDWarD, S.; GoNzálEz-JaéN, M.T.; TEllo, J.C. Fusarium proliferatum isolated from garlic in Spain: Identification, toxigenic potential and pathogenicity on related Allium species. Phytopathol. Mediterr. 2012, 51, 207–218. [Google Scholar]
- Eljounaidi, K.; Lee, S.K.; Bae, H. Bacterial endophytes as potential biocontrol agents of vascular wilt diseases–review and future prospects. Biol. Control. 2016, 103, 62–68. [Google Scholar] [CrossRef]
- Alberts, J.F.; Van Zyl, W.H.; Gelderblom, W.C. Biologically based methods for control of fumonisin-producing Fusarium species and reduction of the fumonisins. Front. Microbiol. 2016, 7, 548. [Google Scholar] [CrossRef]
- Wightwick, A.; Walters, R.; Allinson, G.; Reichman, S.; Menzies, N. Environmental risks of fungicides used in horticultural production systems. Fungicides 2010, 1, 273–304. [Google Scholar]
- Arjumend, T.; Sarıhan, E.O.; Yıldırım, M.U. Plant-Bacterial Symbiosis: An Ecologically Sustainable Agriculture Production Alternative to Chemical Fertilizers. In Revisiting Plant Biostimulants; IntechOpen: London, UK, 2022. [Google Scholar]
- Lin, T.; Zhao, L.; Yang, Y.; Guan, Q.; Gong, M. Potential of endophytic bacteria isolated from ‘Sophora alopecuroides’ nodule inbiological control against Verticillium wilt disease. Aust. J. Crop Sci. 2013, 7, 139–146. [Google Scholar]
- Mousa, W.K.; Shearer, C.R.; Limay-Rios, V.; Zhou, T.; Raizada, M.N. Bacterial endophytes from wild maize suppress Fusarium graminearum in modern maize and inhibit mycotoxin accumulation. Front. Plant Sci. 2015, 6, 805. [Google Scholar] [CrossRef]
- Ramawat, K.G.; Goyal, S. Co-evolution of secondary metabolites during biological competition for survival and advantage: An overview. In Co-Evolution of Secondary Metabolites. Reference Series in Phytochemistry; Mérillon, J.M., Ramawat, K., Eds.; Springer: Cham, Switzerland, 2020; pp. 3–17. [Google Scholar]
- Card, S.; Johnson, L.; Teasdale, S.; Caradus, J. Deciphering endophyte behaviour: The link between endophyte biology and efficacious biological control agents. FEMS Microbiol. Ecol. 2016, 92, fiw114. [Google Scholar] [CrossRef]
- Fravel, D.R.; Connick, W.J.; Lewis, J.A. Formulation of microorganisms to control plant diseases. In Formulation of Microbial Biopesticides; Burges, H.D., Ed.; Springer: Dordrecht, Netherlands, 1998; pp. 187–202. [Google Scholar]
- Khan, M.R. Beneficial bacteria for biological control of fungal pathogens of cereals. In Bacteria in Agrobiology: Disease Management; Maheshwari, D., Ed.; Springer: Berlin/Heidelberg, Germany, 2013; pp. 153–165. [Google Scholar]
- Fira, D.; Dimkić, I.; Berić, T.; Lozo, J.; Stanković, S. Biological control of plant pathogens by Bacillus species. J. Biotechnol. 2018, 285, 44–55. [Google Scholar] [CrossRef] [PubMed]
- Murray, M.; Thompson, W. Rapid isolation of high molecular weight plant DNA. Nucleic Acids Res. 1980, 8, 4321–4326. [Google Scholar] [CrossRef] [PubMed]
- Tamura, S.; Stecher, G.; Li, M.; Knyaz, C.; Kumar, K. MEGA X: Molecular Evolutionary Genetics Analysis (MEGA) across computing platforms. Mol. Biol. Evol. 2018, 35, 1547–1549. [Google Scholar]
- Moyes, R.B.; Reynolds, J.; Breakwell, D.P. Differential staining of bacteria: Gram stain. Curr. Protoc. Microbiol. 2009, 15, A.3C.1–A.3C.8. [Google Scholar] [CrossRef] [PubMed]
- Reiner, K. Catalase test protocol. Am. Soc. Microbiol. 2010, 1–6. Available online: https://asm.org/getattachment/72a871fc-ba92-4128-a194-6f1bab5c3ab7/Catalase (accessed on 20 November 2022).
- Gordon, S.A.; Weber, R.P. Colorimetric estimation of indoleacetic acid. Plant Physiol. 1951, 26, 192. [Google Scholar] [CrossRef]
- Rao, W.S.; Sinha, M. Phosphate dissolving organisms in the soil and rhizosphere. Indian J. Agric. Sci. 1963, 33, 272–278. [Google Scholar]
- Alexander, D.; Zuberer, D. Use of chrome azurol S reagents to evaluate siderophore production by rhizosphere bacteria. Biol. Fertil. Soils 1991, 12, 39–45. [Google Scholar] [CrossRef]
- Etminani, F.; Harighi, B. Isolation and identification of endophytic bacteria with plant growth promoting activity and biocontrol potential from wild pistachio trees. Plant Pathol. J. 2018, 34, 208. [Google Scholar] [CrossRef] [PubMed]
- Faramarzi, M.; Fazeli, M.; Yazdi, M.T.; Adrangi, S.; Al-Ahmadi, K.J.; Tasharrofi, N.; Mohseni, F.A. Optimization of cultural conditions for production of chitinase by a soil isolate of Massilia timonae. Biotechnology 2009, 8, 93–99. [Google Scholar] [CrossRef]
- Wagi, S.; Ahmed, A. Bacillus spp.: Potent microfactories of bacterial IAA. PeerJ 2019, 7, e7258. [Google Scholar] [CrossRef]
- Ma, Z.; Bielenberg, D.; Brown, K.; Lynch, J. Regulation of root hair density by phosphorus availability in Arabidopsis thaliana. Plant Cell Environ. 2001, 24, 459–467. [Google Scholar] [CrossRef]
- Acuña, J.J.; Jorquera, M.A.; Martínez, O.A.; Menezes-Blackburn, D.; Fernández, M.T.; Marschner, P.; Greiner, R.; Mora, M. Indole acetic acid and phytase activity produced by rhizosphere bacilli as affected by pH and metals. J. Soil Sci. Plant Nutr. 2011, 11, 1–12. [Google Scholar]
- Almoneafy, A.A.; Xie, G.; Tian, W.; Xu, L.; Zhang, G.; Ibrahim, M. Characterization and evaluation of Bacillus isolates for their potential plant growth and biocontrol activities against tomato bacterial wilt. Afr. J. Biotechnol. 2012, 11, 7193–7201. [Google Scholar]
- Aramsirirujiwet, Y.; Gumlangmak, C.; Kitpreechavanich, V. Studies on antagonistic effect against plant pathogenic fungi from endophytic fungi isolated from Hottuynia cordata Thunb and screening for Siderophore and indole-3-acetic acid production. Asia-Pac. J. Sci. Technol. 2016, 21, 55–66. [Google Scholar]
- Ramyabharathi, S.; Raguchander, T. Mode of action of Bacillus subtilis EPCO16 against tomato Fusarium wilt. Biochem. Cell. Arch. 2014, 14, 47–50. [Google Scholar]
- Prashar, P.; Kapoor, N.; Sachdeva, S. Isolation and Characterization of Bacillus sp. with In-vitro Antagonistic Activity against Fusarium oxysporum from Rhizosphere of Tomato. J. Agric. Sci. Technol. 2018, 15, 1501–1512. [Google Scholar]
- Rendón-Ramírez, A.; Shukla, M.; Oda, M.; Chakraborty, S.; Minda, R.; Dandekar, A.M.; Ásgeirsson, B.; Goñi, F.M.; Rao, B.J. A computational module assembled from different protease family motifs identifies PI PLC from Bacillus cereus as a putative prolyl peptidase with a serine protease scaffold. PLoS ONE 2013, 8, e70923. [Google Scholar] [CrossRef]
- Bowman, S.M.; Free, S.J. The structure and synthesis of the fungal cell wall. Bioessays 2006, 28, 799–808. [Google Scholar] [CrossRef]
- Mercado-Blanco, J.; Lugtenberg, B.J.J. Biotechnological applications of bacterial endophytes. Curr. Biotechnol. 2014, 3, 60–75. [Google Scholar] [CrossRef]
- Massawe, V.C.; Hanif, A.; Farzand, A.; Mburu, D.K.; Ochola, S.O.; Wu, L.; Tahir, H.A.S.; Gu, Q.; Wu, H.; Gao, X. Volatile compounds of endophytic Bacillus spp. have biocontrol activity against Sclerotinia sclerotiorum. Phytopathology 2018, 108, 1373–1385. [Google Scholar] [CrossRef]
- Bacon, C.W.; Yates, I.E.; Hinton, D.M.; Meredith, F. Biological control of Fusarium moniliforme in maize. Environ. Health Perspect. 2001, 109, 325–332. [Google Scholar]
Disclaimer/Publisher’s Note: The statements, opinions and data contained in all publications are solely those of the individual author(s) and contributor(s) and not of MDPI and/or the editor(s). MDPI and/or the editor(s) disclaim responsibility for any injury to people or property resulting from any ideas, methods, instructions or products referred to in the content. |
© 2023 by the authors. Licensee MDPI, Basel, Switzerland. This article is an open access article distributed under the terms and conditions of the Creative Commons Attribution (CC BY) license (https://creativecommons.org/licenses/by/4.0/).